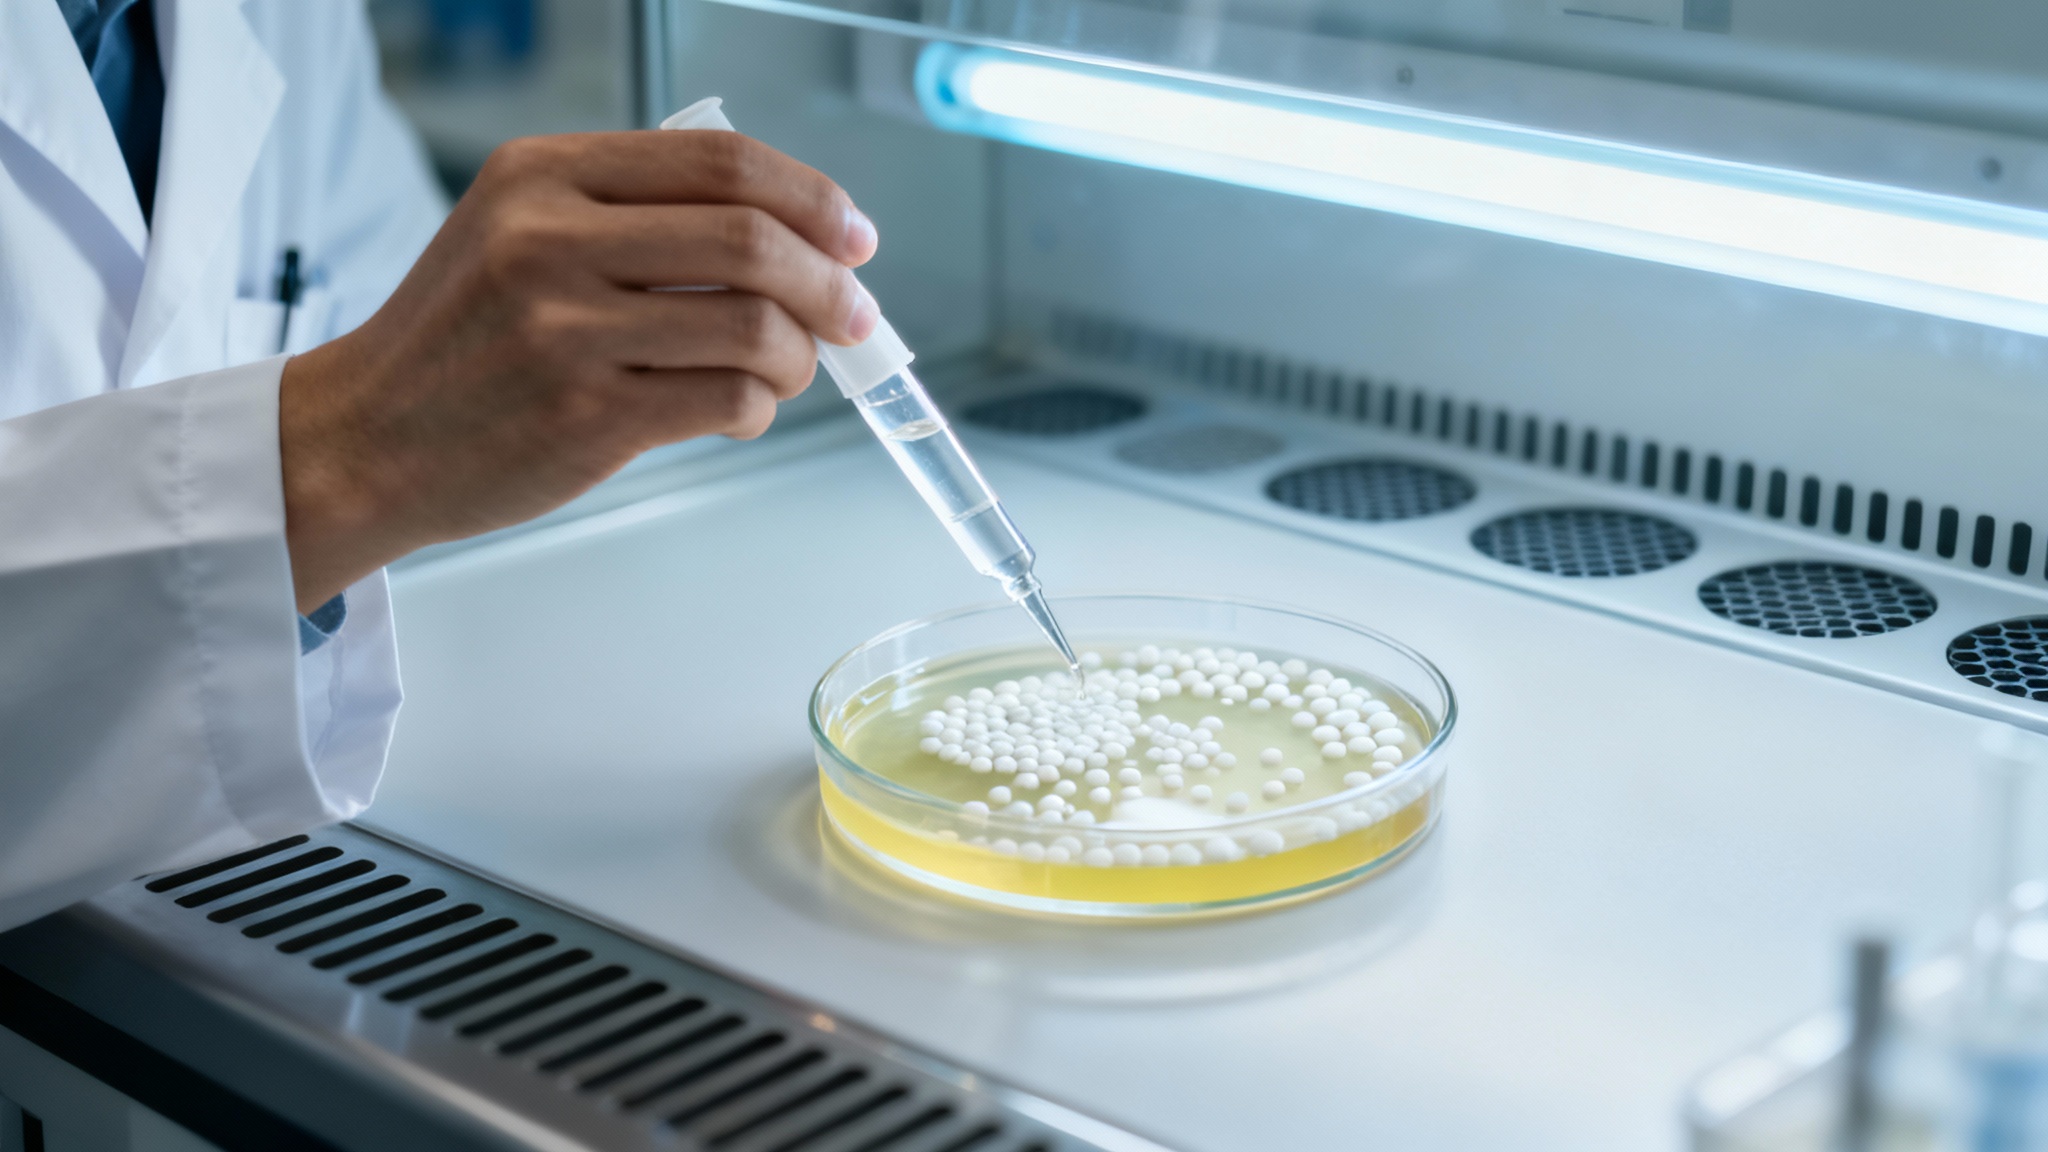
Une usine vivante dans une bactérie du sol

C’est une prouesse qui fascine les biologistes depuis des décennies : la capacité quasi magique du poulpe à se fondre dans son environnement, changeant de couleur et de texture en un clin d’œil. Ce super-pouvoir naturel pourrait bien sortir des océans pour envahir notre quotidien. Des chercheurs de l’Université de Californie à San Diego ont réussi à reproduire en masse le pigment clé de ce camouflage, ouvrant la porte à des applications aussi fascinantes qu’inattendues.
La danse des couleurs sous la peau

Pour comprendre l’exploit, il faut revenir à la biologie de ces créatures. Les poulpes, seiches et autres céphalopodes ne trichent pas : leur peau est une toile vivante. Elle est tapissée de cellules spéciales, les chromatophores, de véritables petits sacs de pigments qu’ils peuvent contracter ou dilater à volonté. C’est ce contrôle musculaire d’une finesse inouïe qui leur permet d’imiter la couleur d’un rocher ou le chatoiement du sable, que ce soit pour échapper à un prédateur ou surprendre une proie.
La xanthommatine, un pigment aussi précieux que fuyant

Au cœur de cette palette de couleurs se trouve un pigment majeur : la xanthommatine. On ne la trouve pas seulement chez les céphalopodes. C’est elle qui donne leur orange éclatant aux ailes des papillons monarques ou le rouge intense aux libellules. Mais voilà le hic : malgré son potentiel, ce pigment est un véritable casse-tête à obtenir. Le prélever dans la nature est complexe, pour des raisons éthiques et écologiques évidentes, et sa synthèse en laboratoire relevait jusqu’ici du bricolage, avec des rendements dérisoires.
Une usine vivante dans une bactérie du sol
Pour contourner cet obstacle, l’équipe californienne, menée par le chimiste marin Bradley Moore, a eu une idée audacieuse : transformer une simple bactérie en usine à pigment. Leur choix s’est porté sur *Pseudomonas putida*, un micro-organisme du sol connu pour sa robustesse et, surtout, pour sa facilité à être génétiquement ‘bricolé’. L’objectif était de lui faire produire une substance qui lui est totalement étrangère, un défi métabolique de taille.
Le contrat : produire ou mourir

Une bactérie, par nature, n’a aucune envie de gaspiller son énergie à fabriquer une molécule inutile à sa survie. Les chercheurs ont donc dû ruser. Ils ont mis au point ce qu’ils appellent une « biosynthèse couplée à la croissance ». En clair, ils ont modifié la bactérie de telle sorte que sa survie dépende directement de la production de xanthommatine. Pour chaque molécule du précieux pigment, la bactérie synthétisait aussi une molécule d’acide formique, essentielle à sa croissance. Un contrat simple : si tu ne produis pas le pigment, tu ne te développes pas.
Des rendements qui changent la donne

Le résultat est sans appel. Alors que les méthodes chimiques traditionnelles peinaient à extraire cinq petits milligrammes de pigment par litre, cette nouvelle approche en génère entre un et trois grammes. C’est un bond de géant, un rendement jusqu’à mille fois supérieur qui rend enfin la production de xanthommatine viable à grande échelle. L’équipe a même poussé le processus plus loin, en utilisant des outils bio-informatiques pour identifier les mutations génétiques qui rendraient leurs petites usines bactériennes encore plus efficaces.
Quand l'armée et les cosmétiques s'en mêlent

Une telle avancée n’a pas tardé à attirer l’attention. Selon les chercheurs, le département de la Défense américain s’intéresse de près à ce pigment pour développer des technologies de camouflage de nouvelle génération. L’industrie cosmétique, elle, y voit un ingrédient potentiel pour des crèmes solaires bio-inspirées. On imagine déjà des peintures capables de changer de couleur ou des capteurs environnementaux basés sur les propriétés de cette molécule tout-terrain.
la nature, une source d'inspiration inépuisable

Si ces applications relèvent encore de la prospective, cette percée illustre une fois de plus à quel point la nature reste une source d’inspiration inépuisable. En décodant les secrets d’un animal aussi singulier que le poulpe, la science ne se contente pas de satisfaire notre curiosité. Elle ouvre des chemins technologiques que nous commencions à peine à imaginer, nous rappelant que les solutions les plus élégantes se trouvent souvent juste sous nos yeux, ou au fond des océans.
Selon la source : trustmyscience.com






